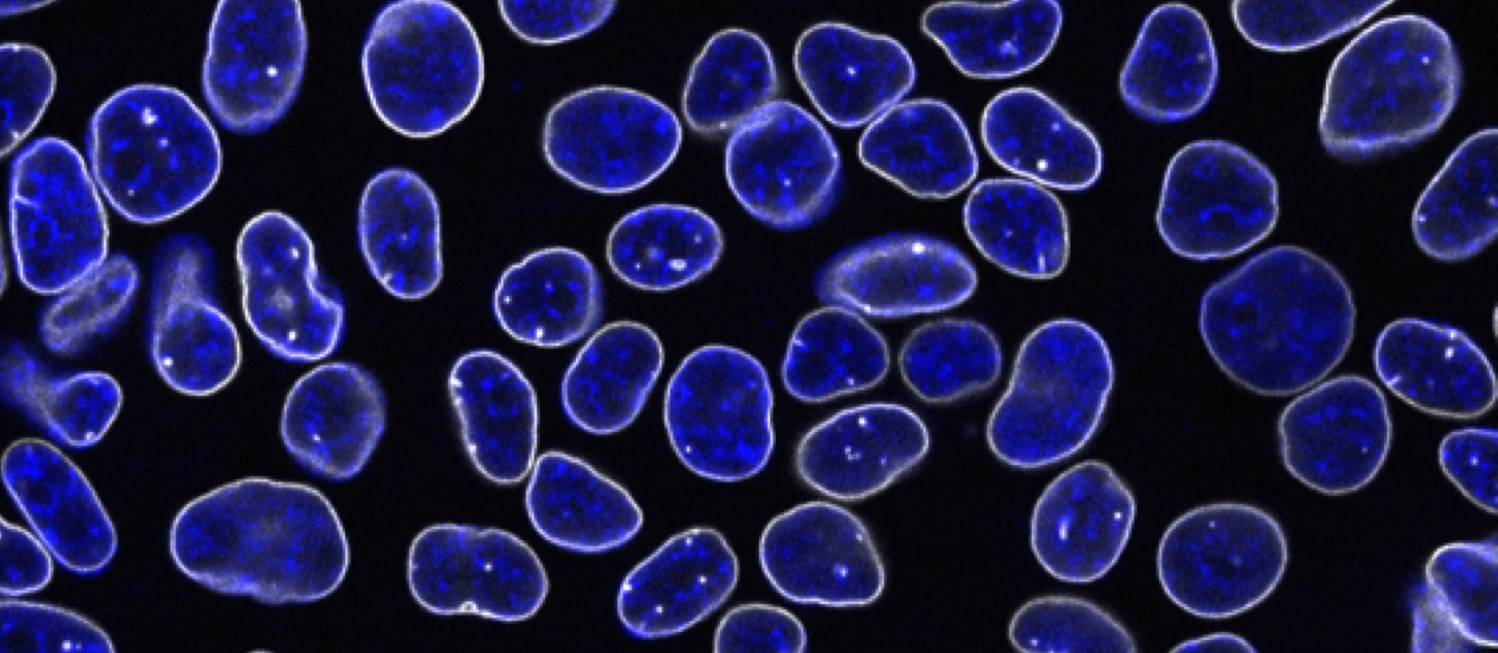

Publications
Full list of publications available on Google Scholar. Below is some recent, relevant work.
In collaboration with the Computational Biology and Mass Spectrometry platforms at CZ Biohub SF, we developed Organelle Profiling, a high-resolution strategy to map subcellular organization using organelle immunocapture coupled to mass spectrometry.
In collaboration with the Computational Biology platform at CZ Biohub SF, we present protoSpaceJAM, an open-source algorithm to automate and optimize gRNA and HDR donor design for CRISPR/Cas insertional knock-in experiments at the genome-wide scale. protoSpaceJAM utilizes biological rules to rank gRNAs based on specificity, distance to insertion site, and position relative to regulatory regions. protoSpaceJAM can introduce ‘recoding’ mutations (silent mutations and mutations in non-coding sequences) in HDR donors to prevent re-cutting and increase knock-in efficiency.
Recent advances in gene editing are enabling the engineering of cells with an unprecedented level of scale. But sorting large numbers of samples is laborious, and to date, no automated system exists to sequentially manage Fluorescence-Activated Cell Sorting (FACS) samples. Here, in collaboration with the Bioengineering platform at CZ Biohub SF, we describe the development of an integrated software and hardware platform to automate FACS, a central step for the selection of cells displaying desired molecular attributes. Automation eliminates operator errors, standardizes gating conditions by eliminating operator-to-operator variations, and reduces hands-on labor by 93%.
In partnership with our colleagues from the Royer lab at the Biohub, we developed cytoself, an innovative deep-learning-based approach for fully self-supervised protein localization profiling and clustering. (See preprint here.)
This paper describes the first release of our flagship OpenCell dataset. We combined CRISPR, confocal live-cell imaging, mass spectrometry and machine learning to map the sub-cellular localization and interactions of 1,310 human proteins. We show that unsupervised clustering of our dataset facilitates biological discovery. (See preprint here.)
In this collaboration with the Weissman lab at UCSF, we used our live imaging and proteomics pipeline to discover new functions for micro-peptides, very short proteins that are encoded all throughout the genome and whose function remains very mysterious.